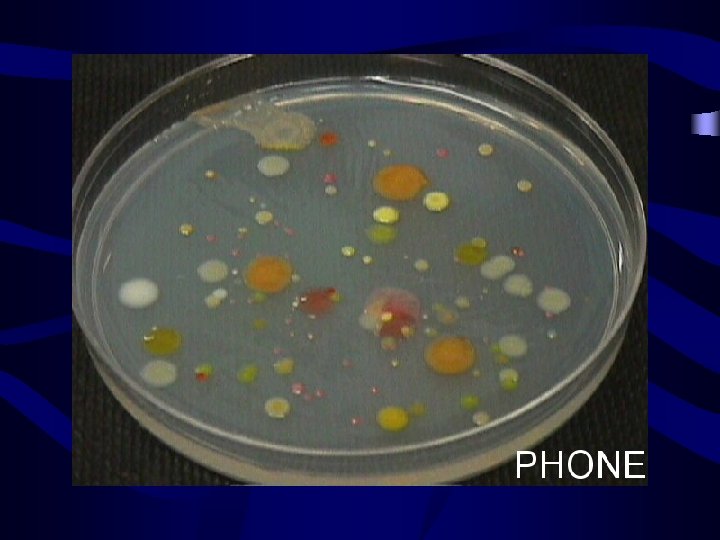
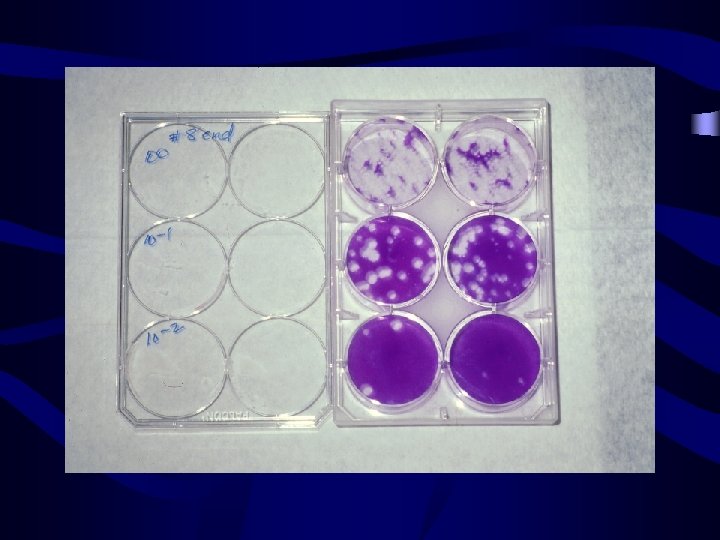

Methods to Detect and Quantify Pathogens Charles P

- Slides: 28
Methods to Detect and Quantify Pathogens Charles P. Gerba Professor Dept. of Soil, Water and Environmental Science University of Arizona
Issues in Detection • Sensitivity – Detection Volume and presence of interfering substances that reduce assay sensitivity • Specificity – is it the right organism or group of organisms • Quantification - precision
Methods and Microbes • No method for concentration and detection is 100% efficient • Microbes are individuals • Microbes are particulates not solutes, and are not necessarily evenly distributed in a given media (air, water, soil)
Cultural/Standard Methods for the Detection of Pathogens in the Environment • Virus – Concentration/separation – Cell culture (one cell line does not detect all) – Serology (identification) • Bacteria – – Concentration/separation Enrichment media Selective media Biochemical tests, serology, immunochemical
Methods for the Detection of Pathogens • Protozoa – Concentration or elution – Purification • Differential centrifugation • Immune Magnetic Separation – Stain with monoclonal antibodies – Observe under UV light – Examine for characteristics • Shape and size • Internal structures
Typical Sample Volumes for Water • Bacteria – 100 ml • Viruses – – Raw Sewage 1 -5 liters Treated sewage 40 liters Surface waters 400 liters Drinking water 400 to 2000 liters • Protozoa – Treated sewage 4 liters – Surface waters 10 to 100 liters – Drinking water 10 to 100 liters
Time and Cost for Assay of Enteric Pathogens in Water • Bacteria – 2 to 5 days; $40 to $200 • Virus – 14 to 60 days; $500 to $1, 200 • Protozoa – 2 to 3 days; $250 to $450
Enumeration of Microbes • CFU Colony Forming Unit • PFU Plaque Forming Unit • MPN Most Probable Number
Steps Involved in the Detection of Waterborne Enteric Viruses and Parasites Sample Collection Concentration Purification Replication Identification Quantification Isolation and/ or Characterization
Noninfected monkey kidney cells
Monkey cells infected with poliovirus
Principles of Protozoan Detection in the Environment • • Filtration of large volumes of water Concentration Purification Method of detection coupled with an ability to quantify the desired microorganisms
Parasite Concentration • Pall Gelman Envirocheck Sampling Capsule • Used for US EPA method 1622 – Protozoa detection: Cryptosporidium and Giardia Envirocheck Sampling Capsule
Methodology (filtration/concentration with Filta-Max) • After a volume of water is passed through a filter cartridge, the eluted solution is then concentrated Filta-Max. TM
Methodology • The concentrate is then purified • This is accomplished by immunomagnetic separation (IMS) Puri-Max. TM
Purification by IMS Parasite cysts or oocyst antibody Paramagnetic microbead
Detection by IF • Detection method is based on an indirect immunofluorescent antibody (IFA) stain 2 o labeled Ab (FITC) Primary antibody or t s st y C cy Oo
Cell Culture-Cryptosporidium Take purified sample expose to 10% bleach for 10 min to inactivate viruses and bacteria, algae, fungi Inoculate sample onto HCT-8 cells Wash and perform excystation Examine cells for evidence of infection and growth of Cryptosporidium life stages • microscope (bright field/IFA) • ELISA • PCR
Aerosol Sampling • • • Impingers Impact- Anderson Aerosol Filters High volume fluid samplers Electrostatic participators Settling plates
Aerosol Sampling • Efficacy affected by – Collection media – Relative humidity – Desiccation